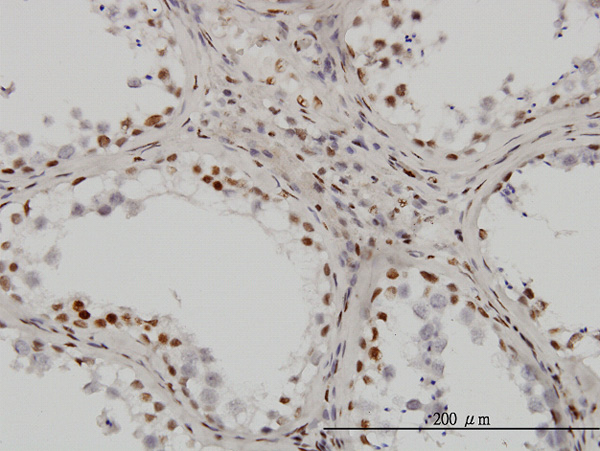

UBTF Antibody (monoclonal) (M01)
Mouse monoclonal antibody raised against a partial recombinant UBTF.
- 产品详情
- 实验流程
- 背景知识
Application
| WB, IHC, IF, E |
|---|---|
| Primary Accession | P17480 |
| Other Accession | NM_014233 |
| Reactivity | Human |
| Host | mouse |
| Clonality | monoclonal |
| Isotype | IgG2a Kappa |
| Clone Names | 6B6 |
| Calculated MW | 89406 Da |
| Gene ID | 7343 |
|---|---|
| Other Names | Nucleolar transcription factor 1, Autoantigen NOR-90, Upstream-binding factor 1, UBF-1, UBTF, UBF, UBF1 |
| Target/Specificity | UBTF (NP_055048, 551 a.a. ~ 650 a.a) partial recombinant protein with GST tag. MW of the GST tag alone is 26 KDa. |
| Dilution | WB~~1:500~1000 IHC~~1:100~500 IF~~1:50~200 E~~N/A |
| Format | Clear, colorless solution in phosphate buffered saline, pH 7.2 . |
| Storage | Store at -20°C or lower. Aliquot to avoid repeated freezing and thawing. |
| Precautions | UBTF Antibody (monoclonal) (M01) is for research use only and not for use in diagnostic or therapeutic procedures. |
For Research Use Only. Not For Use In Diagnostic Procedures.
Provided below are standard protocols that you may find useful for product applications.
BACKGROUND
Upstream binding factor (UBF) is a transcription factor required for expression of the 18S, 5.8S, and 28S ribosomal RNAs, along with SL1 (a complex of TBP (MIM 600075) and multiple TBP-associated factors or 'TAFs'). Two UBF polypeptides, of 94 and 97 kD, exist in the human (Bell et al., 1988 [PubMed 3413483]). UBF is a nucleolar phosphoprotein with both DNA binding and transactivation domains. Sequence-specific DNA binding to the core and upstream control elements of the human rRNA promoter is mediated through several HMG boxes (Jantzen et al., 1990 [PubMed 2330041]).
REFERENCES
1.The maternal nucleolus plays a key role in centromere satellite maintenance during the oocyte to embryo transition.Fulka H, Langerova ADevelopment. 2014 Apr;141(8):1694-704. doi: 10.1242/dev.105940.2.Role of Ooplasm in Nuclear and Nucleolar Remodeling of Intergeneric Somatic Cell Nuclear Transfer Embryos during the First Cell Cycle.Ostrup O, Strejcek F, Petrovicova I, Lucas-Hahn A, Morovic M, Lemme E, Petersen B, Laurincikova N, Niemann H, Laurincik J, Hyttel P.Cell Reprogram. 2011 Apr;13(2):145-55.3.Nuclear and Nucleolar Reprogramming during the First Cell Cycle in Bovine Nuclear Transfer Embryos.Ostrup O, Petrovicova I, Strejcek F, Morovic M, Lucas-Hahn A, Lemme E, Petersen B, Niemann H, Laurincik J, Maddox-Hyttel P.Cloning Stem Cells. 2009 Sep;11(3):367-75.4.Nucleologenesis and embryonic genome activation are defective in interspecies cloned embryos between bovine ooplasm and rhesus monkey somatic cells.Song BS, Lee SH, Kim SU, Kim JS, Park JS, Kim CH, Chang KT, Han YM, Lee KK, Lee DS, Koo DB.BMC Dev Biol. 2009 Jul 28;9:44.
终于等到您。ABCEPTA(百远生物)抗体产品。
点击下方“我要评价 ”按钮提交您的反馈信息,您的反馈和评价是我们最宝贵的财富之一,
我们将在1-3个工作日内处理您的反馈信息。
如有疑问,联系:0512-88856768 tech-china@abcepta.com.























 癌症的基本特征包括细胞增殖、血管生成、迁移、凋亡逃避机制和细胞永生等。找到癌症发生过程中这些通路的关键标记物和对应的抗体用于检测至关重要。
癌症的基本特征包括细胞增殖、血管生成、迁移、凋亡逃避机制和细胞永生等。找到癌症发生过程中这些通路的关键标记物和对应的抗体用于检测至关重要。 为您推荐一个泛素化位点预测神器——泛素化分析工具,可以为您的蛋白的泛素化位点作出预测和评分。
为您推荐一个泛素化位点预测神器——泛素化分析工具,可以为您的蛋白的泛素化位点作出预测和评分。 细胞自噬受体图形绘图工具为你的蛋白的细胞受体结合位点作出预测和评分,识别结合到自噬通路中的蛋白是非常重要的,便于让我们理解自噬在正常生理、病理过程中的作用,如发育、细胞分化、神经退化性疾病、压力条件下、感染和癌症。
细胞自噬受体图形绘图工具为你的蛋白的细胞受体结合位点作出预测和评分,识别结合到自噬通路中的蛋白是非常重要的,便于让我们理解自噬在正常生理、病理过程中的作用,如发育、细胞分化、神经退化性疾病、压力条件下、感染和癌症。